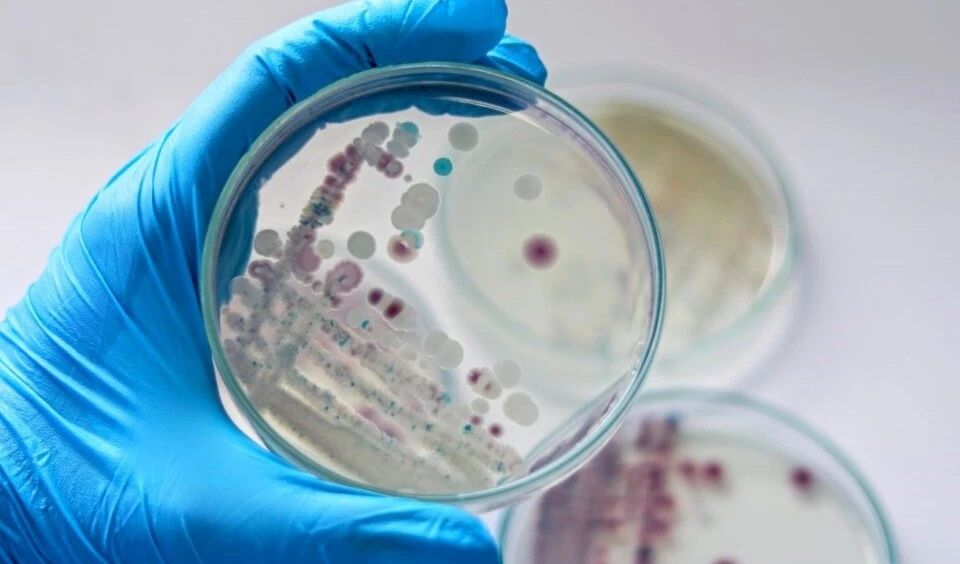
Vinculan aumento de bacteria carnívora en EE.UU. con cambio climático. Foto: Shutterstock.

Los “tours de ratas” aumentan en Nueva York, EE.UU.
Algunos de los guías turísticos de la ciudad agregaron paradas en sitios notoriamente infestados por estos mamíferos.
-

Los “tours de ratas” aumentan en Nueva York. Foto tomada de The Guardian.
Sin un flautista de Hamelín, las ratas gigantes de Nueva York viven entre los túneles subterráneos, en los restaurantes, en las viviendas y en las basuras.
Según una empresa de control de plagas, hay cerca de tres millones de estos roedores, un 50 por ciento más que hace una década.
La clase de estos animales presentes en la megaurbe es grande y más agresiva en comparación con otras especies.
Un estudio de los Centros para el Control y la Prevención de Enfermedades de EE.UU., mostró el riesgo de esos mamíferos para trasmitir más de 30 enfermedades, como la salmonelosis, el tifus y el padecimiento de Lyme.
Mientras tanto, algunos de los guías turísticos de la ciudad agregaron paradas en sitios notoriamente infestados, alertó New York Post.
Desde las redes sociales, otros publicaron videos con el objetivo de llamar la atención de la ciudadanía y las autoridades locales para denunciar el problema.
"La gente pasa, hay ratas corriendo por los pies de la gente, hay montones de basura en la acera", dijo a The Guardian el guía Kenny Bollwerk.
Esta situación plantea un desafío significativo en términos de salud pública y saneamiento para la metrópoli de 8,5 millones de personas.
En la lucha contra estos animales, los ciudadanos pusieron veneno y bombardearon madrigueras con hielo seco, pero muchas de estas medidas resultaron ineficientes.
Las autoridades de Nueva York intentaron también resolver el problema y ordenaron la instalación de contenedores con tapas, además exigieron su obligatorio empleo.